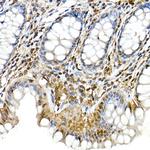
PYCARD Antibody in Immunohistochemistry (Paraffin) (IHC (P))
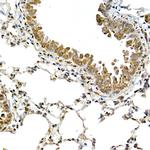
PYCARD Antibody in Immunohistochemistry (Paraffin) (IHC (P))

Search
Invitrogen
PYCARD Polyclonal Antibody
{{$productOrderCtrl.translations['antibody.pdp.commerceCard.promotion.promotions']}}
{{$productOrderCtrl.translations['antibody.pdp.commerceCard.promotion.viewpromo']}}
{{$productOrderCtrl.translations['antibody.pdp.commerceCard.promotion.promocode']}}: {{promo.promoCode}} {{promo.promoTitle}} {{promo.promoDescription}}. {{$productOrderCtrl.translations['antibody.pdp.commerceCard.promotion.learnmore']}}

Please note: We are reviewing Western blot images included in the antibody testing data in our catalog, including those provided by third parties. Unless expressly labeled or annotated as “raw-unedited”, Western blot images included in the antibody testing data in our catalog may have been edited, optimized or otherwise adjusted for presentation.
产品信息
PA5-88132
种属反应
已发表种属
宿主/亚型
分类
类型
抗原
偶联物
形式
浓度
规格
纯化类型
保存液
内含物
保存条件
运输条件
RRID
产品详细信息
Positive Samples: A-549, THP-1; Cellular Location: Cytoplasm, Endoplasmic reticulum, Mitochondrion, Nucleus
Immunogen sequence: LKLLSVPLRE GYGRIPRG
靶标信息
Functions as key mediator in apoptosis and inflammation. Promotes caspase-mediated apoptosis involving predominantly caspase-8 and also caspase-9 in a probable cell type-specific manner. Involved in activation of the mitochondrial apoptotic pathway, promotes caspase-8-dependent proteolytic maturation of BID independently of FADD in certain cell types and also mediates mitochondrial translocation of BAX and activates BAX-dependent apoptosis coupled to activation of caspase-9, -2 and -3. Involved in macrophage pyroptosis, a caspase-1-dependent inflammatory form of cell death and is the major constituent of the ASC pyroptosome which forms upon potassium depletion and rapidly recruits and activates caspase-1. In innate immune response believed to act as an integral adapter in the assembly of the inflammasome which activates caspase-1 leading to processing and secretion of proinflammatory cytokines. The function as activating adapter in different types of inflammasomes is mediated by the pyrin and CARD domains and their homotypic interactions. Required for recruitment of caspase-1 to inflammasomes containing certain pattern recognition receptors, such as NLRP2, NLRP3, AIM2 and probably IFI16. In the NLRP1 and NLRC4 inflammasomes seems not be required but facilitates the processing of procaspase-1. In cooperation with NOD2 involved in an inflammasome activated by bacterial muramyl dipeptide leading to caspase-1 activation. May be involved in DDX58-triggered proinflammatory responses and inflammasome activation. Isoform 2 may have a regulating effect on the function as inflammasome adapter. Isoform 3 seems to inhibit inflammasome-mediated maturation of interleukin-1 beta. In collaboration with AIM2 which detects cytosolic double-stranded DNA may also be involved in a caspase-1-independent cell death that involves caspase-8. In adaptive immunity may be involved in maturation of dendritic cells to stimulate T-cell immunity and in cytoskeletal rearrangements coupled to chemotaxis and antigen uptake may be involved in post-transcriptional regulation of the guanine nucleotide exchange factor DOCK2; the latter function is proposed to involve the nuclear form. Also involved in transcriptional activation of cytokines and chemokines independent of the inflammasome; this function may involve AP-1, NF-kappa-B, MAPK and caspase-8 signaling pathways. For regulation of NF-kappa-B activating and inhibiting functions have been reported. Modulates NF-kappa-B induction at the level of the IKK complex by inhibiting kinase activity of CHUK and IKBK. Proposed to compete with RIPK2 for association with CASP1 thereby down-regulating CASP1-mediated RIPK2-dependent NF-kappa-B activation and activating interleukin-1 beta processing.
⚠WARNING: This product can expose you to chemicals including mercury, which is known to the State of California to cause birth defects or other reproductive harm. For more information go to www.P65Warnings.ca.gov.
仅用于科研。不用于诊断过程。未经明确授权不得转售。
生物信息学
蛋白别名: Apoptosis-associated speck-like protein containing a CARD; mASC; MGC10332; PYD and CARD domain-containing protein
基因别名: 9130417A21Rik; Asc; CARD5; masc; Pycard; TMS-1; TNS1
UniProt ID: (Mouse) Q9EPB4
Entrez Gene ID: (Mouse) 66824, (Rat) 282817




